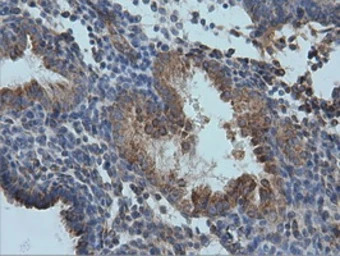
IVD antibody [1B10]

相关产品推荐更多 >
万千商家帮你免费找货
0 人在求购买到急需产品
- 详细信息
- 文献和实验
- 技术资料
- 免疫原:
Full length human recombinant protein of human IVD (NP_002612) produced in HEK293T cell.
- 亚型:
IgG2b
- 形态:
Liquid
- 保存条件:
Store as concentrated solution. Centrifuge briefly prior to opening vial. For short-term storage (1-2 weeks), store at 4ºC. For long-term storage, aliquot and store at -20ºC or below. Avoid multiple freeze-thaw cycles.
- 克隆性:
Monoclonal
- 标记物:
Unconjugated
- 适应物种:
Human, Rat, Dog, Monkey
- 保质期:
12 months from the shipping date of the product.
- 抗原来源:
Human
- 目录编号:
GTX84285
- 级别:
Primary Antibodies
- 库存:
Available
- 供应商:
GeneTex
- 宿主:
Mouse
- 应用范围:
WB, ICC/IF, IHC-P
- 浓度:
1 mg/ml (Please refer to the vial label for the specific concentration.)
- 靶点:
IVD
- 抗体英文名:
IVD antibody [1B10]
- 抗体名:
IVD 抗体 [1B10]
- 规格:
100 μl

WB analysis of HEK293T cells transfected with IVD plasmid (Right) or empty vector (Left) for 48 hrs using GTX84285 IVD antibody [1B10].
Loading : 5 ug per lane

IHC-P analysis of human bladder tissue using GTX84285 IVD antibody [1B10].
Dilution : 1:150

WB analysis of various cell lines using GTX84285 IVD antibody [1B10].
Loading : 35 ug per lane

IHC-P analysis of human breast adenocarcinoma tissue using GTX84285 IVD antibody [1B10].
Dilution : 1:150

IHC-P analysis of human thyroid carcinoma tissue using GTX84285 IVD antibody [1B10].
Dilution : 1:150

IHC-P analysis of human bladder carcinoma tissue using GTX84285 IVD antibody [1B10].
Dilution : 1:150
IHC-P analysis of human prostate carcinoma tissue using GTX84285 IVD antibody [1B10].
Dilution : 1:150

IHC-P analysis of human lymph node tissue using GTX84285 IVD antibody [1B10].
Antigen retrieval : Heat-induced epitope retrieval by 10mM citrate buffer, pH6.0, 100ºC for 10min.
Dilution : 1:50

IHC-P analysis of human endometrium adenocarcinoma tissue using GTX84285 IVD antibody [1B10].
Dilution : 1:150

IHC-P analysis of human kidney tissue using GTX84285 IVD antibody [1B10].
Dilution : 1:150

IHC-P analysis of human liver tissue using GTX84285 IVD antibody [1B10].
Dilution : 1:150

ICC/IF analysis of COS7 cells transiently transfected with IVD plasmid using GTX84285 IVD antibody [1B10].
风险提示:丁香通仅作为第三方平台,为商家信息发布提供平台空间。用户咨询产品时请注意保护个人信息及财产安全,合理判断,谨慎选购商品,商家和用户对交易行为负责。对于医疗器械类产品,请先查证核实企业经营资质和医疗器械产品注册证情况。
 文献和实验
文献和实验【共享】Present and future applications of gold in rapid assays
no reagents other than the protein, diluent buffers, and particles. With defined raw materials, IVD manufacturers can calculate the exact amount of antibody required per particle of gold to give optimal assay performance, which results in cost savings
随着分子诊断学的不断发展,有人认为膜将逐渐失宠。然而,事实绝非如此。在体外诊断(IVD)的发展过程中,膜材料和微孔材料一直长期占据中心地位。硝酸纤维、尼龙等材料制作成膜,这些膜的使用促进了以抗原抗体相互作用为基础的免疫检测的发展,并使这些测定获得了今天所拥有的市场优势地位。膜的使用也使免疫诊断学向侧流照护点检验的改进成为可能,比如今天人们所熟悉的家用孕检工具形式。但是,随着分子诊断学逐渐商业化发展,一些分析家认为膜的作用必将逐渐消失。他们认为,基于抗原抗体相互作用的免疫检测将会被新兴的以核酸
于较低亲和力的相互作用,不能使用经典LowCross Buffer®设置的截止值进行。对于这些分析,LowCross Buffer®MILD可能是有益的。尽管如此,对于大多数应用,LowCross Buffer®的经典配方可完美平衡干扰抑制和真正信号保护。 Figure 3: Improving an RBD-based SARS-CoV-2 antibody ELISA using LowCross-Buffer. Comparison of negative samples (# 1-20
 技术资料
技术资料暂无技术资料 索取技术资料





![MMP1 antibody [6A5]](https://img1.dxycdn.com/2022/0328/260/9306269485103500453-14.jpg!wh200)



![CD63 antibody [AD1] (FITC)](https://img1.dxycdn.com/2022/0328/768/4505777673244400453-14.jpg!wh200)

